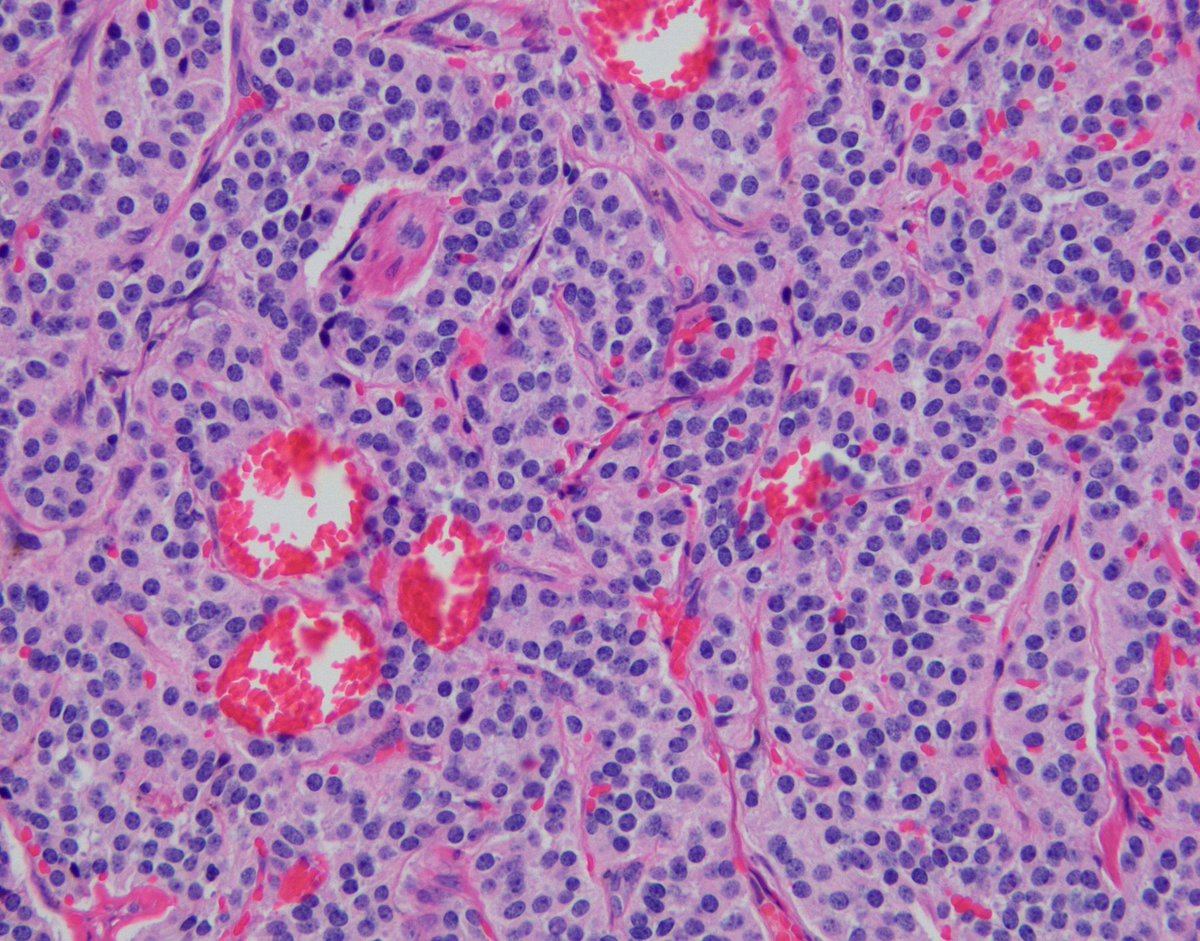
Jared T. Ahrendsen MD, PhD (AP/NP/FP) tweet media

Pediatric Neurooncology Postmortem Research and the Children’s Brain Tumor Network: Impact and Neuropathology Perspectives cdmcd.co/yKAy6z
English
Melissa M. Blessing
1.7K posts


@DrMMB
@TexasChildrens #neuropath #autopsy #forensics #SUID #PediPath.T/RT not advice; my opinions; cases not current. Alum @MayoClinic @BostonChildrens @HarvardMed











#Artinpathology#TwittersChoice Once again, our DLMP 13th annual art in pathology contest is on!!! We have ever more amazing entries this year. Please vote for your Twitter’s choice favorite art at the link below before May 20th 2024. forms.gle/7Q72ZiW9VaTSYw… 📷

Have you listened to The Pediatric and Developmental Pathology Podcast? We can help you find it! Ask your smart device to play The Pediatric and Developmental Pathology Podcast Search your favorite podcast app, or click the links on our podcast page: pedidevpath.podbean.com